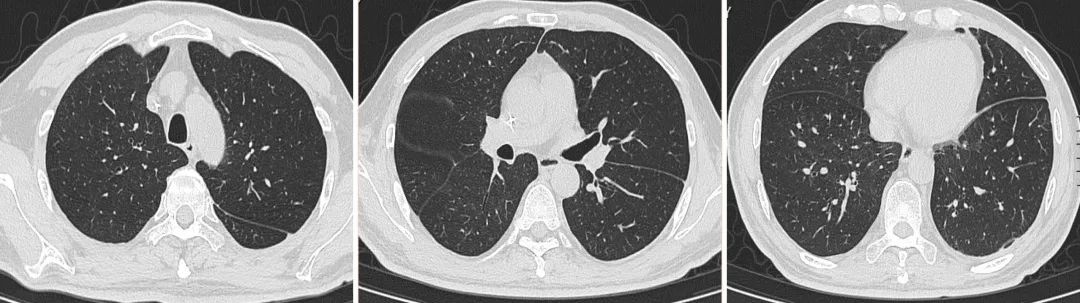
间质性肺病治疗后会加重吗,化疗后肺部间质性的病变

- 现病史:
患者,男性,52岁,以「确诊弥漫大B细胞淋巴瘤5月余,发热2月」于2020.8.12收入我科。患者2020年3月初无明显诱因出现左上腹部轻度刺痛不适,在外院行上腹部CT发现脾占位,行PET-CT检查示恶性肿瘤伴脾内多发转移可能性大。
于2020-03-13在外院行胰体尾切除术+全脾切除术,术后病理:(脾脏)弥漫大B细胞淋巴瘤。术后行R-CHOP方案化疗共四次,于2020.7初结束。具体方案为:利妥昔单抗600mg d0+多柔比星脂质体50mg d1+环磷酰胺1275mg d1+长春新碱2mg d1+泼尼松100mg d1。每次化疗结束,服用泼尼松片50mg bid五天。从第二周期开始,化疗结束后均会出现白细胞减少等骨髓抑制表现。06.15化疗期间因白细胞升高明显,腹部CT提示腹腔积液和感染,给予腹腔引流,最多每天引流1000ml。本次入院前100ml/天,黄色。
患者7月份以来一直发热。外院07.13胸部CT:两肺多发磨玻璃影。07.14血培养(右侧)示革兰氏阳性菌。予哌拉西林舒巴坦,伏立康唑和万古霉素抗感染治疗,但患者仍有发热。07.17复查胸部CT提示两肺多发磨玻璃影较前进展。调整抗生素为美罗培南联合哌拉西林他唑巴坦,加用甲强龙等治疗,一周后胸部CT两肺多发磨玻璃影较前明显好转,但诊断不明确。停用甲泼尼龙后再次出现发热。08.01胸部CT:两肺间质改变伴少许炎症,予以抗细菌及抗真菌治疗未好转,仍然反复出现发热。考虑膈下淋巴瘤复发致发热可能,计划下一步拟行放疗,就诊于我院放疗科。
入院后,放疗科诊断:脓毒症、弥漫大B细胞淋巴瘤。入院后,予以氟康唑治疗,效果不佳,改为哌拉西林他唑巴坦联合卡泊芬净抗感染治疗5天,病情逐渐恶化,持续高热并出现呼吸衰竭,复查胸部CT:双肺弥漫性磨玻璃影。以「I 型呼吸衰竭(面罩吸氧4L/min,SPO2 85-89%)」,转入我科进一步诊治。
否认既往「高血压病、慢性肺部疾病」等慢性病史;否认结核病史。否认青霉素等药物过敏史;否认食物过敏史。否认有毒有害物质接触史。术后出现血糖升高,以胰岛素控制。已婚已育,配偶及子女体健。
入院查体: T 38.6C,BP:106/88 mmHg。SPO2:92%(FiO2 41%)。神清,气促,口唇发绀,气管居中。双肺呼吸音粗,呼吸音弱,双侧肩胛下区可闻及细湿啰音。心率108次/分,律齐,各瓣膜听诊区未闻及病理性杂音。左上腹轻触痛不适,无反跳痛、肝肋下未及。双下肢无浮肿,无杵状指(趾)。
入院诊断:
1、呼吸衰竭、弥漫性肺病;2、腹腔感染 胰瘘;3、弥漫大B细胞淋巴瘤术后,膈下淋巴瘤复发可能;4、继发性糖尿病。
诊治经过
一、 最初诊治阶段:双肺弥漫性病变+腹腔感染(2020.08.12-2020.08.28)
入院后实验室检查: 血常规:20-08-12 WBC 2.14 10^9/L ,N 90.2%, L 5.1%, L绝对数 0.11 10^9/L, Hb 108.0 g/L , BPC 174 10^9/L。CRP 169.90mg/L,PCT 0.870 ng/mL,肝功能、肾功能、电解质:钾4.04mmol/L,钠133.9 mmol/L, 肌酐42 umol/L,尿素3.80mmol/L,白蛋白25g/L, 天门冬氨酸氨基转移酶144 U/L ,丙氨酸氨基转移酶27 U/L ,LDH 1167 U/L。D-二聚体 3.950 mg/L FEU, 08-14:CD3 49.3 % 偏低, CD4 29.7 % , CD8 21.5 % , CD4/CD8 1.38。
治疗方案: (1)经鼻高流量氧疗。(2)对症支持治疗:给予人免疫球蛋白 10g 静滴 qd;交替输注人血白蛋白与新鲜血浆;纠正水、电解质紊乱;护肝、护胃等。(3)抗感染治疗:考虑淋巴瘤化疗后免疫缺陷状态,继发性感染可能性大,故予加强腹腔引流,每天引流100ml,反复腹腔积液涂片找细菌及培养,美罗培南+万古霉素覆盖细菌,卡泊芬净 50mg 静滴 qd抗真菌;(4)不除外淋巴瘤化疗药物美罗华等诱导的机化性肺炎可能,遂予以静脉甲强龙80mg抗炎治疗。经治疗2天后患者氧合有所改善。
为尽快明确诊断,入院第2天在麻醉科密切配合下行全麻下支气管镜肺泡灌洗+冷冻肺活检术(右下叶外侧基地段)。取材共5块,术后少量出血。结果示:BALF常规:颜色淡黄色,透明度微浑,细胞计数 500 10^6/L, 细胞分类(中性) 9 %,细胞分类(巨噬细胞)10 %。细胞分类(淋巴)CD3 63.7 % 偏低,CD4 12.2 % 偏低,CD8 45.3 % 偏高,CD4/CD8 0.3 偏低。腹水培养:肺炎克雷伯菌。
两天后结果回报BALF PCR扩增后,肺孢子菌特异性核酸片段扩增阳性。
BALF六胺银染色,发现肺孢子菌结构。2020.08.16肺泡灌洗液病原体高通量测序回报:耶氏肺孢子菌 序列数1856,同时外周血CD4+淋巴细胞低于200个。结合上述结果,予确诊为:非HIV免疫缺陷耶氏肺孢子菌肺炎(Pneumocystis jiroveci Pneumonia, PJP)。


【图1】肺泡灌洗液行PJP相关检查的结果: A肺泡灌洗液标本经PCR扩增后,肺孢子菌特异性核酸片段扩增阳性。B肺泡灌洗液经六胺银染色,发现肺孢子菌囊结构。

【图2】肺冷冻活检组织病理结果
立即调整治疗方案:复方磺胺甲噁唑片0.96 口服 q8h联合卡泊芬净50mg 静滴 qd,并碳酸氢钠片碱化尿液。同时,考虑非HIV引起PJP大多不主张使用糖皮质激素,停用甲强龙,并加强控制腹腔感染:持续引流腹水,使用生长抑素减少胰瘘,加强支持治疗,丙种球蛋白 20g/日,连用5天,白蛋白20g/日,并交替输注血浆。
经过一周治疗,患者肺部CT显示双肺磨玻璃渗出及实变较前好转,但体温仍在38C左右。再次调整治疗方案,复方磺胺甲噁唑片 1.34g口服,tid。腹腔引流液培养出嗜麦芽糖寡养单胞菌,调整抗生素为头孢哌酮舒巴坦3.0g Q8h加丁胺卡那0.4g Q12h。右侧出现胸水,予以穿刺引流,胸闷症状明显改善。并继续使用糖皮质激素(为停用后再次加用,对其使用原因的讨论请见后文),逐渐减量5天后停用。上述治疗后,体温逐渐下降,并于5天后恢复正常;氧合逐渐好转,一周后可鼻导管吸氧,一般情况、食欲开始好转。
入院时胸部CT(08.12)

8.18

8.26

9.03

【图3】治疗期间胸部CT变化
08.18腹腔引流液

【图4】入院后腹腔引流液性状
2、第二阶段:腹腔感染明显好转,引流管拔出。但再次出现发热(2020.08.29-2020.09.02)
经积极抗感染治疗方案后,腹腔积液明显吸收,遂拔除腹腔引流管。复查血常规提示淋巴细胞已升至正常范围,炎症指标不高,肝肾功能正常。舒普深、阿米卡星已停用半月。

【图5】治疗进程中血清淀粉酶的变化

【图6】治疗整个进程中淋巴细胞绝对值(蓝色)的变化与体温间(红色)的关系
但患者8月29号再次出现发热,最高体温38.2℃,伴干咳和左侧胸闷、胸痛。无腹痛、腹泻等其他不适。体格检查:左下肺叩诊浊音,左肺呼吸音低,左上腹无压痛和反跳痛。SpO2 98-100%, D-二聚体3.950mg/L。复查胸部CT: 两肺散在纤维条影及模糊影,较前好转。左侧胸腔及叶间裂包裹性积液,较前增多。遂行胸腔积液穿刺置管,引流出酱油色胸水150ml 。胸水常规示李凡他试验 + ,细胞计数 2000 10^6/L 偏高, 细胞分类(中性) 90 % , 细胞分类(淋巴) 5 % , 细胞分类(巨噬细胞) 5 %;胸水细菌涂片找到革兰氏阴性杆菌少量。调整抗菌药物:美罗培南 1g 静滴 q8h。经上述治疗后,2020.09.06患者体温正常。
3、第三阶段:出现气胸
2020.09.07患者左侧胸腔引流接袋出现胀气,并引流出少量血性液体,考虑出现出现气胸,予改接水封瓶行闭式引流。可引流出大量气泡。经持续引流一周后,再无气泡溢出。 复方磺胺甲噁唑片及卡泊芬净治疗21天,予以停用。继续美罗培南联合莫西沙星抗感染治疗。
4、第四阶段:再次出现发热并左侧胸腔积液 - PJP反复
2020.09.12 再次出现发热,伴干咳及乏力。
胸部CT:1. 两肺散在炎症,较前相仿;左侧液气胸、叶间裂积气积液。予以左侧胸腔穿刺引流。胸水:棕褐色,细胞计数 775*10^6/L,细胞分类:中性:75%,淋巴:22%,胸水送细菌和真菌检查。
腹部检查:腹部超声:脾脏切除术后,局部包裹性积液量很少。上腹部CT:1.胰体尾切除术+全脾切除术后;局部包裹性积液,胰头周围及中上腹部肠系膜间隙渗出影,较前有吸收好转。再次出现发热,不能完全排除腹腔感染因素,加用阿米卡星注射液 0.2g 静滴 q12h 及注射用头孢哌酮钠舒巴坦钠 3g 静滴 q8h抗感染治疗。
09.13

【图7】治疗过程中出现左侧自发性气胸
2020.09.16 Xpert结核分枝杆菌rpoB基因和突变检测:Xpert MTB 阴性。
胸水结果回报:特殊染色提示真菌,胸水六安银染色下见零星散在深褐色球形真菌,部分存在皱缩、自溶现象,结合该病人革兰染色剂荧光染色下非常规酵母样真菌特征,高度疑似肺孢子菌。
再次调整治疗方案:加用复方磺胺甲噁唑片 0.96g 口服 tid、卡泊芬净 50mg 静滴 qd抗真菌治疗。当天夜间体温即恢复正常。继续加强支持治疗等。10.13,胸部CT复查 双肺野清晰,胸水吸收。
5、第五阶段:PJP及腹腔感染好转,放疗阶段:
2020.09.11 PET-MRI:1、淋巴瘤术后化疗后,左心膈角区团块状软组织异常信号影,FDG代谢异常增高,考虑局部活性肿瘤病灶, 2、左膈肌增厚FDG代谢增高伴左膈下积液,考虑炎性病变伴包裹性积液;胰尾旁包裹性积液。3、右肺炎症。根据该结果,考虑膈下淋巴瘤复发。由于当前PJP控制可,经与放疗科、肿瘤科多学科讨论后,拟对膈下活性肿瘤病灶行放疗。2020.10.29 放疗25次后结束出院。
【图8】经治疗后,10.13复查胸部CT扫描结果
讨论
本例患者救治成功的体会和关键点
一、及时的介入诊疗手段为临床决策提供了坚实的依据。
患者为弥漫性大B细胞淋巴瘤术后,化疗四次,方案为含有美罗华的R-CHOP方案,并含有糖皮质激素;过程中有白细胞下降, 腹腔感染,使用广谱抗生素及糖尿病史,肺部弥漫性病变的病因是R-CHOP方案药物引起的间质性肺炎,还是免疫缺陷引起的肺部感染?感染的病原体?尽早行支气管镜检查并支气管肺泡灌洗,包括冷冻肺活检,快速明确诊断,对患者预后影响极大。
对这类严重的肺部弥漫性疾病患者,实施经支气管冷冻肺活检 (transbronchial cryobiopsy,TBCB) 如何避免术中发生出血和气胸,加重病情,我们中心的体会:
1、操作者术前通过胸部CT对病灶血供、病灶区域内及病灶周围的血管分布情况进行初步判断;
2、临床上双肺上叶、中叶血管较密集,出血几率较大,尤其是右肺中叶,大出血常常发生在中叶病变活检,针对弥漫性肺疾病,优先考虑肺下叶行冷冻肺活检。此外靠近肺门的内中2/3处,有伴行、软骨保护不全的中等大小血管,活检易致大出血且不能获得细支气管和肺组织,故常选择肺外带距离胸膜1-2cm处行冷冻肺活检,在避免出血的同时有效减少气胸的发生。
3、术中再次置入超声小探头探查目标部位血供情况,避免误伤中等大小的血管。
4、避免气胸采取的措施:ILD通常选择在病变最显著的远端肺实质,需避免纤维化或蜂窝肺最严重的部位,应在病灶相对正常组织交界部位做活检,此外胸膜下区域的组织对于UIP的诊断有很大的意义,但距离胸膜<1 cm进行活检会显著增加气胸发生风险。一般在x光透视引导下进行TBCB,伸入冷冻探头至轻抵脏层胸膜后探头应缩回1-2 cm并在此处活检。
二、 与微生物室密切合作,多种检测技术联合快速检出感染病原体:
1、从支气管肺泡灌洗液.镜检染色检出肺孢子菌滋养型或包囊获得诊断PJP的直接证据,同时肺泡灌洗液的分析较之痰检不仅提供较高诊断率,也排除其他诊断或合并感染,如结核病、组织胞浆菌病、巨细胞病毒等。
2、近年发展的以PCR 为核心的分子生物学技术以其快速,取材方便、检测简便、敏感度和特异度高的特点,被广泛应用于PJP 的检测,尤其对非HIV PJP患者诊断有优势。
3、NGS技术在非典型病原体的检测中具有很大的优势。该患者BALF中被检测到耶氏肺孢子菌序列数1856,进一步验证了传统实验室检测的结果。
4、不同诊断测试的组合,包括(1,3)β3诊断葡聚糖实验(G实验) 被指南推荐用于PJP准确快速诊断,直接改善患者预后。
三、 注重支持治疗及脏器功能保护。
整个救治过程中,贯穿始终:加强支持治疗,尽早康复锻炼,并注意保护肝肾功能。
四、激素短程并避免大剂量使用,减少后续混合感染出现。
迄今为止,与HIV合并PJP患者建议使用糖皮质激素不同,对非HIV合并PJP患者使用糖皮质激素无明确定论。我们确诊后很快停用了激素,但患者体温出现反复,后继以短期小剂量使用一周后停用。我们体会,对于病情严重者早期、短程使用,对减轻患者全身症状有益。而大剂量激素使用并广覆盖抗生素等可能导致混合感染,反而使得氧合和肺部损伤再恶化,从而导致救治失败。
五、复方磺胺甲噁唑的疗程及剂量应个体化。
现今国内外文献均推荐磺胺治疗PJP疗程21天。根据最新美国最大循证医学数据库Uptodate网站推荐,磺胺治疗疗程21天,后续减量治疗避免复发。
的确,本病例磺胺连用卡泊芬净,使用21天后停用,但体温再次反复,再次出现胸腔内耶氏肺孢子菌感染,降低剂量的磺胺联合卡泊芬净使用共35天直至肺部渗出及胸水吸收后才停用。因利妥昔单抗可致 B 细胞耗竭减少持续数月并损害体液免疫;加之病变范围广、程度重,对这类病情严重的患者,治疗疗程应延续至病变完全吸收为止。值得注意的是,在此过程中还需注意保护肝肾功能以及加强支持治疗等联合措施。
背景知识
一、利妥昔单抗在弥漫性大B细胞淋巴瘤化疗中的作用及其PJP发生的机制
CHOP方案是侵袭性非霍奇金淋巴瘤的标准治疗方案,而R-CHOP方案,即化疗前加用利妥昔单抗是弥漫性大B细胞淋巴瘤治疗的经典和一线治疗方案。
利妥昔单抗是一种嵌合单克隆抗体,针对B细胞特异抗原CD20。CD20抗原是一种III 跨膜蛋白,在造血干细胞等正常细胞中无表达,但在肿瘤细胞中稳定表达,利妥昔单抗以CD20 抗原为靶点,*伤杀**B细胞减少B细胞数量,减少B细胞分泌的抗体,与其他化疗药物联合治疗非霍奇金淋巴瘤能显著提高疗效。
利妥昔单抗在外周血和淋巴组织中有很强的B细胞消耗活性。循环CD20单剂量利妥昔单抗治疗复发性B细胞淋巴瘤患者外周血中B细胞迅速减少。在B细胞恶性肿瘤患者中,利妥昔单抗的消除是靶向介导的(即,药物与B细胞上的CD20结合可在初次输注时清除血清中的抗体,导致淋巴结处可触及的CD20结合位点减少或饱和)。研究表明,在连续4周每周给药后外周血利妥昔单抗的药物浓度成倍上升,且药物半衰期持续下降。由于利妥昔单抗对CD20+细胞的持续作用,可致可诱导强效和长期 B 细胞耗尽,这种耗竭可能持续数月,损害抗体生产。
B细胞在CD4+ T细胞生成保护肺内免于抵御肺部PJP感染中起着至关重要的作用。PJ感染的防御主要以细胞免疫为主,其中T细胞尤其是CD4 细胞起很大作用。CD4 细胞通过细胞因子激活肺巨噬细胞,从而吞噬PJ。B细胞的减少导致CD4+ T细胞生成不足,从而增加了耶氏肺孢子菌肺炎感染的风险。通常CD4细胞低于200/μL就可能引起感染。
二、利妥昔单抗与非HIV患者感染PJP
自2006年以来,由于利妥昔单抗的广泛应用,PJP的发病率迅速上升。许多研究表明,利妥昔单抗治疗增加了淋巴瘤患者PJP的风险。据报道,这些患者的发病率可高达10.04~13.04%。影响PJP发生的因素很多,联合皮质类固醇的使用,化疗间隔更短,白细胞减少特别是CD4+淋巴细胞在我们的荟萃分析中。报道了采用双周方案治疗的患者有更高的PJP风险PJP在患者中的风险更高。利妥昔单抗治疗的淋巴瘤患者的PJP的临床过程可能是非常暴发性的,死亡率高,据报道高达33.3%。鉴于PJP增加的发病率和潜在病死率,预防的作用已被研究,预防治疗对于预防PJP的发生非常有效。
同样,以前的系统回顾报告了PJP预防的有效性在免疫缺陷的非HIV患者。12个随机试验,其中包括1245名接受自体骨髓或实体器官移植的患者接受过移植手术或患有血液癌的患者也包括在综述中。当使用TMP/SMZ时,PJP发生率降低91%。
除利妥昔单抗广泛应用于B细胞肿瘤的治疗特别是CD20阳性非霍奇金淋巴瘤(NHL)治疗外,也被应用于治疗一些其他疾病以及韦格纳肉芽肿病,SLE,造血干细胞移植,类风湿关节炎,难治性肾病综合征等,随着利妥昔单抗应用的增多,利妥昔单抗引起的不良反应不断被报道。
同时,研究表明,除引起高死亡率的PJP外,利妥昔单抗引起的肺部并发症中最严重的也包括间质性肺炎(IP),很难鉴别 PJP 和利妥昔单抗治疗引起弥漫性肺疾病(RILD)。在一项 613 例淋巴瘤患者接受利妥昔单抗治疗的研究中,PJP 发生率为 3.4% ,RILD发生率为 6.2%。两者的鉴别尽早的支气管镜检查实施肺泡灌洗以及肺活检是根本办法。
三、PJP的发病机制与影像学特征
1、PJP的发病机制
PJP的发病机理及病理基础是PJ的滋养体破坏Ⅰ型肺泡上皮细胞膜,使细胞坏死及毛细血管通透性增加,肺泡内充盈含有滋养体的嗜酸性渗出物、纤维蛋白、和脱落的上皮细胞。同时Ⅱ型肺泡上皮细胞增殖修复受损的肺泡毛细血管膜,肺间质内巨噬细胞、浆细胞和淋巴细胞增殖导致间质改变。影像学表现为: 实变及磨玻璃影、小叶间隔增厚、支气管血管束周围间质增厚、小叶内间质增厚、胸膜下间质增厚、牵引性支气管扩张、肺气囊、马赛克征、碎石路征、纵隔淋巴结增大等。其中,实变、磨玻璃影可能为滋养体破坏Ⅰ型肺泡上皮细胞膜所致渗出改变。小叶间隔增厚、支气管血管束周围间质增厚、小叶内间质增厚、胸膜下间质增厚、牵引性支气管扩张、碎石路征等为Ⅱ型肺泡上皮细胞增殖修复受损的肺泡毛细血管膜,肺间质内巨噬细胞、浆细胞和淋巴细胞增殖导致间质改变,磨玻璃影亦可能为弥漫性间隔增厚所致。
2、典型PJP的影像学特征
PJP在HRCT上展示了各种不同的表现。在非HIV PJP患者来说,主要特征是弥漫广泛的毛玻璃影(GGO),代表肺泡内纤维蛋白,碎片和微生物聚集的肺泡炎。GGO的分布通常是对称的,主要在肺门区域和上叶,与外周。57%的人患者有马赛克征。初始的针对性治疗可引起放射学的迅速改善,相反,无效治疗或非特异性治疗与马赛克征和结构变形和肺渗出密度增加有关。三分之一的病人,典型的PJP后遗症,包括结构变形(即线性变形),不规则斑片影、囊状和牵拉性支气管扩张,74%的病人在27天后痊愈 (平均60天,范围11302天)
3、不典型影像学特征
小于20%在病例中,PJP可表现为GGO的不典型分布,局灶范围或下叶优势。由于GGO可能是宿主免疫介导的肺损伤的结果,GGO 会在非HIV患者中很快发展为实变。结节和/或小叶间隔重叠增厚共存(即铺路石征)是另一种HRCT表现。肺囊肿在非HIV患者中较之艾滋病毒阳性患者少见(3% vs. 56%)。它们的形成被归因于长期低强度炎症过程导致组织破坏。可发生气胸或纵隔气肿。在罕见情况下,PJP可表现为单发或多发肺结节大小不等,反映肉芽肿性炎症。当结节是唯一的表现时,PJP的诊断在HRCT和BAL上都可能被忽略。

【图9】典型的非HIV患者PJP的HRCT表现。A:冠状面HRCT图像重新格式化突出了上叶的主要受累。B:HRCT显示双侧对称毛玻璃样浑浊,胸膜下区域分布为主,但胸膜下豁免征。C和D 不典型PJPHRCT :C:结节样;D:囊样表现。引自参考文献2.
四、PJP的病原学检查方法
由于PJP难以培养,传统PJP的诊断主要依赖于从呼吸道分泌物,痰液或支气管肺泡灌洗液中,通过显微镜涂片和染色方法检出肺孢子菌滋养型或包囊形态,是诊断PJP的直接证据。高渗盐水诱导痰是一种侵袭性较小的方法,但敏感性较低,为55-90%。应首选BALF。
没有条件行肺泡灌洗液检查者,痰液检查需留取患者24 h痰液或用喷雾吸人法刺激咳嗽,诱导患者咳出较多痰量。咳后的痰尾液内菌体数量较多。应注意留取。
由于非HIV免疫缺陷患者大多PJ真菌负荷和载量较低,显微镜下方法的灵敏度在为非HIV感染者低于HIV感染者,镜下涂片染色方法比较挑战。
PCR是一种重要的另外一种诊断方法,特别是在非HIV感染患者,与染色法相比,诊断率明显增加。实时qPCR是首选。这种方法能够检测非常低的真菌负荷和载量。PCR的灵敏度>显微镜(常规染色); BAL液中的qPCR 敏感性94-99%,特异性89-91%。
另外,一种高灵敏度的诊断方法是血清(1,3)-糖- d -葡聚糖(G实验)测定,以较高的阴性PJP感染的预测价值为特征,作为PJP感染的指标。G实验对排除PIP有助。然而, 它不能作为PJP的单一诊断试验。如果G实验阳性应启动尽快的纤支镜检查。对不能开展支气管镜检查的单位有帮助,对重症PJP结合显著增高的LDH 具有诊断提示意义。
诊断指南通常推荐联合不同的方法学,如镜检(免疫荧光和常规染色)和qPCR。有研究证实G实验水平与qPCR存在相关性。提示G实验反映了肺部的真菌负荷。有文章提出G实验水平在PJP患者多为>500甚至> 1000pg /mL,远高于80 pg/m截断值。
五、PJP的治疗:
1、治疗药物的选择
推荐TMP-SMZ作为非艾滋病毒感染任何严重程度的PJP患者的治疗首选。
肾功能正常的患者的TMP 15患者的任何严 和 SM 75患者的任何严重程度的提天静脉注射或口服,分三到四次。病人接受静脉注射治疗直到临床稳定和胃肠道功能正常。一些接受TMP-SMX治疗的患者会出现高钾血症,特别是肾功能不全和老年患者,以及接受高剂量TMP-SMX的患者和钾代谢异常的患者。建议接受TMP-SMX治疗后定期监测钾水平。
严重程度的替代药物:
当TMP-SMZ不能使用时的方案:克林霉素加伯氨喹,甲氧苄氨嘧啶加氨苯砜、阿托伐喹和静脉注射喷他脒; 不能服用TMP-SMX的方案选择取决于疾病的严重程度。对于轻度患者可选择阿托伐琨,克林霉素加伯氨喹,TMP +氨苯砜,所有这些药物都可以口服。口服阿托伐喹更被推崇用于轻度疾病患者。
对于中度疾病的选择:克林霉素加伯氨喹,TMP +氨苯砜;克林霉素加伯氨喹更被多用。
重度疾病包括:克林霉素静脉注射加口服伯氨喹,静脉注射喷他脒。对于严重的疾病,倾向于静脉注射克林霉素+口服伯氨喹,因为比静脉注射的喷他脒毒性小。
克林霉素静脉注射直到临床稳定并胃肠道功能正常,后换为口服克林霉素。克林霉素联合伯氨喹的疗效在一项荟萃分析中得到证实,该荟萃分析对456名HIV患者和41名确诊为PJP的HIV-未感染患者进行抢救治疗,传统的抗肺孢子菌治疗没有改善。克林霉素和普氨喹的联合治疗是对这类患者最有效的替代治疗。喷他脒不常使用,因为它与大量毒性有关(如低血压、低血糖、肾毒性和胰腺炎)。
2、治疗疗程和持续时间
非HIV感染的PJP患者的治疗时间尚未得到充分研究。考虑到非HIV感染患者的暴发性表现和不良预后,建议治疗21天。
临床恶化可能发生在前48天的治疗。病情恶化通常不表示免疫重建炎症反应综合征或治疗失败。这可能是由于抗菌素诱导的肺内微生物溶解引起的炎症反应(这可能就是类固醇有帮助的原因)。此迅速恶化治疗期间,密切监测呼吸频率和氧合非常重要。
一般非HIV的PJP患者应在7天的治疗开始显示临床改善。患者通常在抗PJP治疗21天后症状好转。根据美国最大循证医学数据库Uptodate网站推荐(www.uptodate.com),在完成治疗疗程后,患者应继续接受减少剂量的抗菌素治疗,以防止复发感染(即二次预防)。
3、糖皮质激素的使用
对于HIV感染的中度或重度PJP患者,推荐使用糖皮质激素辅助治疗,由于使用可改善临床结果和死亡率,而不会增加其他机会性感染的风险。
与HIV患者相比,关于糖皮质激素治疗未感染HIV患者PJP的疗效的数据有限。鉴于非HIV感染患者暴发性经过和高死亡率,中到重度PJP患者肺部炎症程度更高,有建议使用糖皮质激素治疗患者。一项对30名非HIV感染的严重PJP患者的回顾性研究表明,16名患者接受了相当于≥患者接受了的PJP强的松与每天接受相当于≤的松与每强的松治疗或糖皮质激素逐渐减量治疗的14名患者相比,每天接受机械通气、重症监护病房住院和补充氧合的时间显著缩短,但机械通气率和住院死亡率相似。另一项对31名未感染艾滋病病毒的PJP患者的回顾性研究也发现,糖皮质激素治疗组和未治疗组在机械通气需求或死亡率方面没有差异。现有的有限数据不能为非感染HIV的PJP患者常规使用皮质激素提供证据。
我们的体会,对重度患者早期使用非大剂量,短疗程的糖皮质激素对改善氧合和全身状况有益。
六、临床特征和预后:
PJP表现为非特异性的体征和症状,如发热、干咳和呼吸困难的发生率分别为86%、76%和81% [2]。在某些情况下感染可引起ARDS。血清CD4+ t细胞计数常<200/ mol / L。一种快速、非特异性肺损伤标志物LDH升高明显,特别是在最严重的情况下。
非HIV患者病情快速进展的风险高于HIV阳性,系统症状少,且从临床发病到诊断时间短。总体死亡率很高(31%),当PJP没有得到适当和快速的治疗时,几乎达到100%。严重形式的PJP可伴有ARDS,尤其在非HIV患者,病情危急,无创呼吸机失败率较高,与表现相似的HIV阳性患者相比死亡率更高。
在没有恰当治疗的情况下,非HIV感染PJP患者死亡率为90%至100%。非HIV PJP的患者治疗结果比感染HIV的患者差; 感染HIV的患者中PCP的死亡率约为10%至20%,而没有感染艾滋病毒的患者中PJP的死亡率为35%至50%。非HIV的PCP患者较高住院率和重症监护病房入院率,严重的PJP与较高的死亡率有关。
感染控制:PJP住院患者应采取标准预防措施,但他们不应与其他免疫功能低下的患者共处一室,因为这可能导致人与人之间的传播。
七、PJP的预防:
我们建议对以下高危人群进行PJP预防: 患者接受相当于≥者接受相当的皮质激素剂量强的松。
1个月或更长的时间内每天服用,且有其他免疫缺陷的患者;异基因造血细胞移植者和实体器官移植受者;急性淋巴细胞白血病患者;接受某些免疫抑制药物治疗的患者和自体造血细胞移植受者,建议进行PJP预防;
建议使用大剂量糖皮质激素(议使用大剂量糖皮治疗的风湿性疾病患者强的松每日服用1个月或更长时间预防PJP,同时服用第二种免疫抑制药物,特别是乙酰毒*药性**物(例如环磷酰胺)。
对于大多数需要预防PJP的患者,我们推荐TMP-SMX,对于肾功能正常的患者,TMP-SMX采用每日一片或每周三次每日一片的方式。TMP 80 mg/SMX 400 mg 每天服用,或者加倍剂量TMP 160 mg/SMZ 800 mg) 每天或者1周服用三次均可。
参考文献:
[1] Xuqin Jiang, Xiaodong Mei, Di Feng, et al, Phylaxis and Treatment of Pneumocystis jiroveci Pneumonia in Lymphoma Patients Subjected to Rituximab-Contained Therapy: A Systemaic Review and Meta-Analysis PLOS ONE,2015, 24;10-16.:
[2] Anna Dallortoa, Anna Candonib, Stefano Volpettib, Pneumocystis jirovecii pneumonia at chest High-resolution Computed Tomography (HRCT) in non-HIV immunocompromised patients: Spectrum of findings and mimickers. European Journal of Radiology,2019,116,116 -127.
[3] L.J. Avino, S.M. Naylor, A.M. Roecker, Pneumocystis jirovecii pneumonia in the non-HIV- infected population, Ann. Pharmacother. 2016, 50: 673-679.
[4] Charles F Thomas, Jr, and Andrew H Limper, Treatment and prevention of Pneumocystis pneumoniain HIV-uninfected patients Treatment and prevention of Pneumocystis infection inpatients with HIV UpToDate Dec 06, 2019 www.uptodate.com.
[5] Helmut J. Salzera, Guido Schäferc, Martin Hoenigle, et al, Clinical, Diagnostic, and Treatment Disparities between HIV-Infected and Non-HIV-Infected Immunocompromised Patients with Pneumocystis jirovecii Pneumonia, Respiration 2018, 96:52-65.
[6] Petra Rogina and Miha Skvarc, Diagnostic accuracy of (1-3)-β-D-glucan to predict Pneumocystis jirovecii pneumonia in non-HIV-infected patients,2020; 54: 221-226.
[7] Cooley L, Dendle C, Wolf J, et al. Consensus guidelines for diagnosis, prophylaxis andmanagement of Pneumocystis jirovecii pneumonia in patients with haematological andsolid malignancies, Intern Med J 2014; 44:1350.
作者:上海市同济大学附属东方医院呼吸与危重症医学科 - 朱晓萍 冯宇 赵江南 高少勇 罗志兵 李强
专家介绍


本文完
*今条头日**排版:大奔